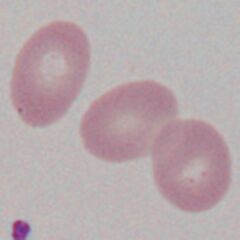

Ovalocytes
From haematologyetc.co.uk
Derivation: latin ovum - egg
Appearance.
An erythrocyte that is rounded, but which has a length that exceeds its diameter is oval. Although the word can be synonymous with an ellipse, in morphological usage the term ovalocyte is used when cell length is less than twice the diameter the cell.
Images Ovalocytes are regular rounded cells that are elongated. The term ovalocyte can be applied to cells where the length is greater than the width, but is not yet twice the width (at which point the cell is more often referred to as an elliptocyte). This form arises in many different contexts although the most familiar is with megalobastic anaemias (look for related features such as hypersegmented neutrophils).
Significance
For ovalocytes that are large, consider: oval macrocytes of megaloblastic states, and the very large (stomatocytic) ovalocytes that are part of of S.E.Asian ovalocytosis. In these cases the additional diagnostic blood appearances are crucial. Where ovalocytes are not enlarged they generally form part of a spectrum of cells e.g. in hereditary elliptocytosis or as part of the dyserythropoietic spectrum in a range of disorders (myelodysplasia, iron deficiency etc).
Pitfalls
Ovalocytes should be distinguished from other elongated forms (elliptocytes or pencil cells) and can arise as part of the spectrum of elliptocytes where they may be better considered as part of that context. Particularly look for those forms that have particular diagnostic significance (see below)
Causes
| INHERITED DEFECTS |
|---|
| S.E.Asian Ovalocytosis A specific disorder that results from structural and functional defects of the band 3 protein causing ovalocytes with a stomatocytic appearance. |
| MEGALOBLASTIC STATES |
| Look for characteristic oval macrocytes in the context of typical hypersegmented neutrophils and other features of these disorders |
| AS PART OF A SPECTRUM OF ABNORMAL CELLS |
| Ovalocytes may form as the first stage in elliptocyte formation - consider whether the cells are simply early elliptocytes |
| Ovalocytes and elliptocytes are present in low number in a range of disorders, in those conditions it is best to focus on the dominant features of the film |
Clinical Examples
Clinical Image 1: A large ovalocyte within the context of normally sized red cells. Note also the slit like central pallor of many of the cells. Image: S.E.Asian ovalocytosis
Clinical Image 2: Multiple oval-shaped cells in the context of general macrocytosis (compare with the nucleus of the included normal small lymphocyte). Image: B12 deficiency
Clinical Image 3: More severe megaloblastic anaemia with very prominent large macrocytic cells. In this case the overall fragility of the developing abnormal erythrocytes has also produced small fragmented cells that cause an apparent reduction in the overall MCV. Image: B12 deficiency
Pathobiology
Ovalocytes in inherited or dyserthropoietic disorders arise by similar mechanism to elliptocytes having an unstable cytoskeleton that allows them to be deformed by shear-stress; in this case there are a range of forms with different severity. In some instances however they may arise because of a particular defect - the classic ovalocyte arises in S.E.Asian ovalocytosis where the transmembrane protein "band 3" is defective at its binding site with other elements of the erythrocyte cytoskeleton - causing a relatively rigid cell structure. The defect is widespread in S.E.Asian populations and may provide resistance to invasion of the erythrocyte by malarial parasites.